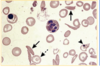

sepsis
- Sepsis is a life-threatening illness caused by the body’s response to an infection.
- Recognising sepsis is often very difficult in children as symptoms and signs can be similar to self- limiting or less severe conditions.
- Bacterial infections are by far the commonest cause of sepsis (can be viral or fungal).
- Sepsis is defined as suspected/proven infection with Systemic Inflammatory Response (SIRS).
presentation of sepsis
SIRS is the presence of at least 2 of the following:
One of which must be temperature or WCC
- Core temperature > 38.5oC or < 36oC.
- Tachycardia (in absence of external stimuli). Tachypnoea for age (or ventilation).
- White cell count elevated or depressed

screening for sepsis

managment of sepsis

anaphylaxis
- Severe, life-threatening allergic reaction that is acute in onset and can cause death.
differentials for anaphylaxis
- Skin: Acute urticaria.
- GUT: Food poisoning, gastroenteritis.
- Respiratory: URTI, irritant rhino-conjunctivitis, choking, viral wheeze. acute asthma exacerbation.
- CVS: vasovagal syncope, panic attack.
presentation of anaphylaxis
- Angioedema same pathophysiology as urticaria, however occurs in deeper layer of the skin with no itch receptors therefore not itchy like acute urticaria

management of suspected anaphylaxis

classic history for acute urticaria
- Woke this morning with rash:
- Raised erythematous plaques.
- Some have pale centre.
- Rash spreading; plaques coalescing.
- Rash intensely pruritic.
- Agitated, irritable and unhappy.
- No previous allergies; eats all foods.
- No recent new contact – food, drug.
acute urticaria background
- Also called hives, wheals or welts.
- Common condition affecting up to 20% of population.
- Typically intensely pruritic erythematous plaque.
- May be associated with angioedema (swelling).
- Commonly categorized by chronicity:
- Acute: <6 weeks; triggers allergy, URTI, idiopathic.
- Chronic: >6 weeks; spontaneous or physical triggers
presentation of acute urticaria
Presentation
- Intensely pruritic rash
- Agitated, irritable, unhappy
- Spreading rash
- Raised erythematous plaques

management of acute urticaria
- History and examination to make diagnosis.
- In new-onset acute urticaria where assessment does NOT suggest underlying cause, NO investigations; may consider FBC and CRP if worried about vasculitis.
- High-dose non-sedating antihistamines.
- ± Oral glucocorticosteroids.

paracetamol overdose protocol overview 1/2

history for paracetamol overdose
o Dose
o Timing
o Associated ingestions
paracetamol overdose protocol overview 2/2

management of paractermaol overdose
charcoal only if very recently ingested
defintive treatment: N-acetylcysteine infusion

differential diagnosis

* Pre-septal cellulitis.
* Orbital or Post-septal cellulitis. * Allergicconjunctivitis.
* Bacterial conjunctivitis.
* Trauma.
* Sub-periostal/orbital abscess. * Cavernous sinus thrombosis.
history and examiantion for red swollen eye
- Acuity of onset?
- Recent URTI?
- Local insect bite, impetigo or conjunctivitis?
- Trauma?
- Eye pain, visual acuity, headache?
- Erythema/swelling of lid/surrounding tissue.
- Conjunctiva – white or red/swollen.
- Impaired eye movement (ophthalmoplegia).
- Painful eye movements.
- Impaired visual acuity.
presentation of pre-septal and orbital cellulitis
Pre-septal cellulitis
- Ocular itching is a prominent symptom.
- Bilateral conjunctival redness and swelling.
- Symptoms on exposure.
**Conjunctivitis ** - Redness and discharge from one eye.
- Affected eye ‘stuck shut’ in the morning.
- Colour/consistency depends on cause.
- Caused by bacteria (Staph. Aureus, H. Strep,
H. Influenzae) chlamydia, viruses.
pre-septal vs orbital cellulitis
Pre-septal cellulitis: inflammatory disease of the orbit limited to the tissues anterior to the orbital septum.
Orbital cellulitis: inflammatory disease of the superficial and deep structures of the orbit.

aetiology of pre-septal cellulitis
- 85%+ cases are pre-septal cellulitis.
- Commonly follows URTI and sinusitis (ethmoid commonest).
- Respiratory pathogens (Streptococcus, Haemophilus) commonest.
- Other sources: spread from skin, lachrymal ducts, middle ear etc.
examiantion for pre-septal vs orbital (more serious) cellulitis

management of pre-orbital sepsis
- Admit.
- IV access.
- FBC/CRP, cultures.
- Nose swab.
- IV Ceftriaxone.
- ± IV Metronidazole
- (if sinuses involved)
- Prompt ENT and
Ophthalmology
review. - 4h obs.
- Consider CT scan.
pneumonia differentials
- Bronchiolitis (Viral CAP). * Pertussis.
- Heart failure.
- Sepsis.
- Metabolic acidosis.
- Non-infectious mimics.